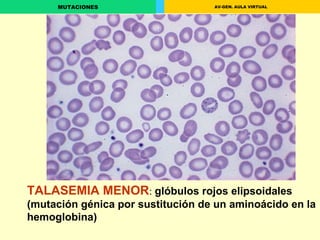
TALASEMIA MENOR :  glóbulos rojos elipsoidales (mutación génica por sustitución de un aminoácido en la hemoglobina)

Las mutaciones son cambios al azar o provocados en el material genético celular que tienen baja probabilidad en organismos superiores y mayor en bacterias y virus. Pueden ser espontáneas o inducidas por agentes mutagénicos como radiaciones o químicos. Las mutaciones pueden ser génicas, cromosómicas o genómicas y tener efectos neutros, perjudiciales o beneficiosos.